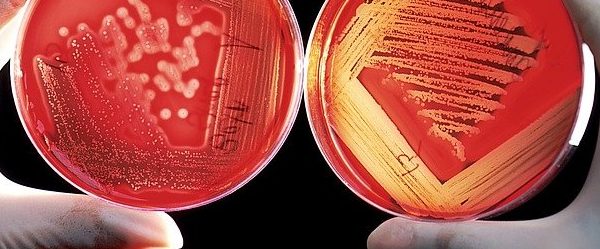

El món que ens envolta és complex i amb interaccions i per això la mirada sistèmica de la ciència ens ajuda a copsar aquesta complexitat. Aquesta és la raó per presentar aquests materials didàctics organitzats a partir de disciplines: Biologia, Física, Geologia i Química.